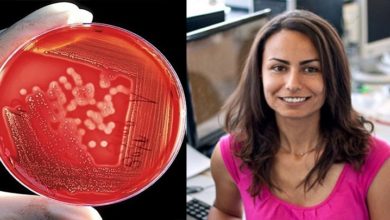

Santé
-
انتخاب أحلام بلحاج كاتبة عامة جديدة لنقابة الأطباء الاستشفائيين
تم مساء أمس 10 جويلية 2019 انتخاب أحلام بلحاج كاتبة عامة جديدة لنقابة الأطباء الاستشفائيين، خلال مؤتمر النقابة العامة للأطباء وأطباء…
Lire la suite » -
باحثة تونسية تنجح في تطوير طريقة لاكتشاف مرض “سرطان الدم” في مرحلة مبكرة
تمكّنت الباحثة التونسية،ندى الرداوي، من تطوير طريقة جديدة تسمح باكتشاف مرض سرطان الدم في مرحلة مبكرة، ضمن مشروع اشتغلت عليه…
Lire la suite » -
في متابعة لحادثة الرضع …وفاة رضيع أصيل معتمدية قرمبالية بعد 32 يوم من المعانات
أكد مراسل اكسيجان اف.م بنابل نقلا عن شهود عيان أن من بين الرضع المتوفين رضيع أصيل عمادة جبل طريف من…
Lire la suite » -
وزارة الصحة: بـــــلاغ حول حالات وفاة بالمستشفى الجهوي محمد التلاتلي بنابـل
سجّل قسم طب الأطفال والولدان بالمستشفى الجهوي محمد التلاتلي بنابل ستّ حالات وفاة وذلك على امتداد ثلاثة أيام وبالتحديد بين…
Lire la suite » -
PODCAST »وزيرة الصحة بالنيابة سنية بالشيخ: « وفاة الرضع كانت طبيعية ولا روابط مشتركة بينها
. قدمت اليوم الثلاثاء 25 جوان 2019 وزير الصحة بالنيابة سنية بالشيخ أسباب وفاة 6 رضع في المستشفى الجهوي محمد…
Lire la suite » -
PODCAST « المدير الجهوي للصحة بنابل: « وفاة الرضع معزولة ولم تكن ناجمة عن عدوى
أكدت اليوم المديرة الجهوية للصحة بولاية نابل، دلال الزواوي، أن كافة الفرق بالمندوبية الجهوية للصحة قد تحولت إلى قسم الولدان…
Lire la suite » -
محرزية العبيدي: تدعو لفتح تحقيق يحدد المسؤوليات في أقرب وقت في حادثة وفاة 6 رضع بنابل
محرزية العبيدي.. تدعو لفتح تحقيق يحدد المسؤوليات في أقرب وقت في حادثة وفاة 6 رضع بنابل نشرت منذ قليل النائب…
Lire la suite » -
نابل-مستشفى محمد التلاتلي: وفاة 6 رضّع بقسم الولدان
كشفت المديرة الجهوية للصحة في نابل دلال الزواوي الباروني عن وفاة 6 رضع في قسم الولدان بمستشفى محمد التلاتلي بولاية…
Lire la suite » -
العاصمة: ضبط طبيب وممرض بصدد اقتناء الزطلة أثناء أوقات العمل
تمكن أعوان دورية تابعة للشرطة العدلية بسيدي حسين السيجومي مساء امس من ضبط و إيقاف طبيب وممرض يعملان بأحد المستشفيات…
Lire la suite » -
منظمة الصحة العالمية توصي بـ قاهرات الجوع والعطش
مع بدء شهر رمضان المبارك كل عام، يبدأ المسلمون بتداول نصائح بشأن أطعمة ومشروبات من شأنها تخفيف الشعور بالجوع والعطش…
Lire la suite »